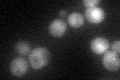
YDL134C
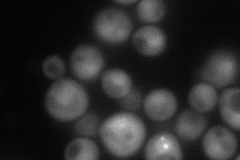
YDL134C
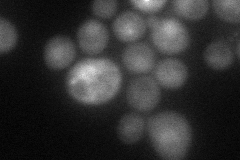
YDL134C
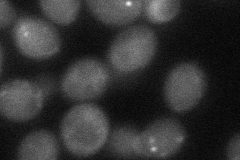
YDL134C

View description
Catalytic subunit of protein phosphatase 2A (PP2A), functionally redundant with Pph22p; methylated at C terminus; forms alternate complexes with several regulatory subunits; involved in signal transduction and regulation of mitosis
Localization:
Intensity:
Fold change:
Significance:
-
C’ GFP library in SD
cytosol36.48 -
N' NOP1pr-GFP in SD
cytosol92.6834 -
N' TEF2pr-mCherry in SD
nucleus54.4974 -
N' NATIVEpr-GFP in SD

nucleus18.2604 -
N' TEF2pr-VC and Cyto-VN in SD
cytosol39.5925 -
C’ GFP library in SD+DTT

cytosol42.641.16No -
C’ GFP library in SD+H2O2

cytosol45.771.25No -
C’ GFP library in Starvation Media

cytosol53.31.46Yes -
C’ GFP library on the background of Pup2-DaMP

cytosol -
C’ GFP library on the background of CCT mutant

cytosol35.69970.978376No
